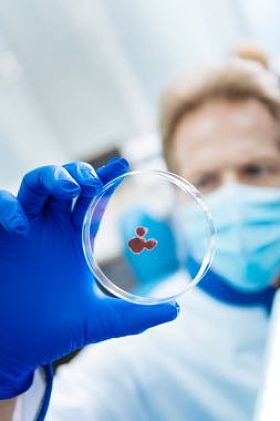
确定的科学家观察血液样

陶瓷砖样
图片基本信息
图片ID:46748
图片大小:7.28MB
图片尺寸:4288 x 2848 像素
颜色模式:RGB
文件格式:JPG
推荐软件:PS,AI
用途:工业
构图:横图
版权说明:如需购买商用授权,请购买企业VIP
授权对象:企业,个人
图司机为设计师提供高清陶瓷砖样图片版权下载,图片为工业,大小为7.28MB,尺寸为4288 x 2848px,更多关于蓝色,设计,装饰,特写,存储,棕色,图案,陶瓷,堆栈,广场,近代,房子,首页,刚硬,显示,平铺,灰色,展厅风采,示例,地板,理石,样本,关闭商用高清版权图片,快来图司机免费下载吧。